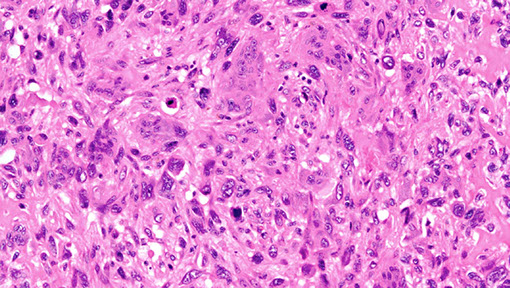

Pancreas
Anatomy, Embryology and Histology
Pancreatic cysts
Pancreatic insufficiency
Acute Pancreatitis
Autoimmune pancreatitis
Chronic Pancreatitis
Nesidioblastosis
Cysts
- Congenital, Pseudocyst, Megacyst
Pancreatic Intraepithelial Neoplasia (PanIN)
Pancreatic Ductal Adenocarcinoma
Pancreatic NeuroEndocrine Tumors (PanNET)
Acinar cell carcinoma
Colloid carcinoma
Pancreatoblastoma
Serous (mucinous) cystadenoma
Mucinous cystic neoplasms
Intraductal Papillary Mucinous Neoplasm (IPMN)
Medullary carcinoma
Osteoclast-Like Giant Cell Carcinoma
Solid PseudoPapillary Neoplasm
Embryology
Develops from a larger dorsal and a smaller ventral bud
- by 4 WGA 2 outpockets from endodermal lining of duodenum develop as ventral and dorsal pancreatic buds, each c its own duct
- ventral part forms the head and the dorsal the head, body and tail
By 12 WGA pancreatic acini develop from ducts
- endocrine cells first seen at base of differentiating exocrine acini by 12-16 WGA
As pancreas matures, amount of connective tissue between lobules decreases (do not mistake with fibrosis)
Anatomy
Histology
Exocrine elements (acini and ducts)
- secrete digestive enzymes into duodenum
Acinar cells arranged as single cell layer surrounding a lumen; nuclei are round and basally located c apical granular red cytoplasm
*** nuclei are EXO (on the outside) ***
Endocrine elements (islets of Langerhans)
- 2% of pancreatic mass
Round central nuclei c pale amphophilic cytoplasm and do not form acini, made of anastomosing cords of endocrine cells (A, B, D and F cells that each secrete their own hormones) and a vascular component
*** nuclei are ENDO (central) ***
- core of islets of Langerhans are mostly insulin-producing B cells and the mantle has A, D and F cells

Pancreatic insufficiency
Due to cystic fibrosis, obstructing cancer, chronic pancreatitis.
Malabsorption of fat-soluble vitamins results (DEAK!)
Dx: Fecal elastase > 200 ug/g
Tx: Pancreatic enzyme replacement and low fat diet
Cystic fibrosis (CF)
Cystic fibrosis transmembrane receptor (CFTR) gene is on 7q31.2
- there is a wide range of mutations with over 1000 described. CFTR encodes a chloride channel expressed in respiratory tract, GI tract, skin adnexa, hepatobiliary system, pancreas and male reproductive tract
- CF is the MC AR condition among Caucasians, c carrier freq 1 in 25; affects ~1 in 2000 live births
- 1st manifestation usually meconium ileus
- nasal polyps in kiddos suggests CF
- male infertility caused by congenital bilateral absence of the vas deferens (CBAVD)
- liver disease results from biliary obstruction
- recurrent bacterial bronchitis and pneumonia may lead to bronchiectasis, pulmonary infx in childhood that is caused by S aureus, B cepacia or P aeuginosa is strong presumptive evidence of CF
- severity and range of manifestations vary c genotype and a variety of contributing factors; eg MPO activity
MC CFTR gene mutations: delta-F508 (2/3), G542X (2%), G551D (1.6%), N1303K (1.3%)
Pearson syndrome
AD pancreatitis and marrow failure
- chromosomal breakage syndrome affecting the mitochondrial DNA
- marrow shows sideroblastic anemia with vacuolization of precursors
- the molecular defect is a microdeletion within the mitochondrial DNA
Johanson-Blizzard syndrome - hypoplasia of the nasal alae, pancreatic exocrine insufficiency with pancreatic lipomatosis, hypothyroidism, and deafness
Schwachman-Diamond syndrome
A pancreatic lipomatosis syndrome with marrow failure and exocrine pancreatic insufficiency
- the pancreas demonstrates fatty metamorphosis; pancreatic islets are preserved
- mutations in SBDS (Shwachman-Bodian-Diamond syndrome)
Type I (insulin dependent) diabetes mellitus (DM1)
DM1 is an autoimmune disease
- HLA-DR3 and HLADR4 heterozygotes have a 10 fold increased risk; homozygotes have a 10 fold increased risk
- 1st degree relatives of affected persons have a higher than avg risk
- siblings have a 5-10% chance of developing it, and identical twins have ~60% concordance
Maturity onset diabetes of the young (MODY)
Noninsulin dependent diabetes with AD inheritance
- responsible for ~5% type 2 DM
- multiple genetic forms
Acute Pancreatitis
Inciting event causing damage to the pancreatic parenchyma leads to autodigestion of pancreas by means of pancreatic enzyme release
- inciting events: *** GET SMASHED! **** Gallstones, EtOH, Trauma, Steroids, Mumps, Autoimmune, Scorpions, Hypercalcemia/lipidemia, ERCP, Drugs (sulfas)
- positive feedback cycle causes pancreatic edema and fat necrosis
Sx: epigastric pain that radiates to the back, nausea/vomiting
- Cullen sign: bluish discoloration around belly-button from hemoperitoneum
- Grey-Turner: bluish-red discoloration around flanks
Dx: Best initial labs: amylase and lipase
- most specific: CT (c oral and IV contrast)
Ranson's criteria (used on admission / initial presentation):
***GA LAW*** Glu > 200, AST > 250, LDH > 350, Age > 55 yo, WBC > 16k
- to predict mortality at 48 hrs after admission:
*** Calvin and HOBBeS *** : Ca2+ > 8, Hct decrease >10%, PaO2 < 60 mmHg; BUN inc > 5, Base deficit > 4 mEq/L, Sequestration of fluid > 4L
-- low Ca2+ assoc c the worst prognosis
Pseudocysts get drained c needle if enlarging/painful
- all abscesses get drained after 10 days
May be complicated by DIC or ARDS
Tx: "Pancreatic rest": NPO, IV fluids, pain control PRN, give abx (imipenem / meropenem) c >30% necrosis
- if gallstones are the cause, do cholecystectomy
- do NOT give IV Calcium unless absolutely necessary, and if you do put pt on heart monitor!
Autoimmune pancreatitis
May be suggested by (+)-hx of other autoimmune dz's (Sjogrens, UC, and PSC), can form a mass mimicking adenocarcinoma
- affects middle aged females
3 types (?):
Type 1 - lymphoplasmacytic sclerosing type pancreatitis; Older pts (7th decade), usually male
Sx: Periphlebitis and frank vasculitis
Micro: Benign ducts surrounded by dense lymphoplasmacytic inflam and expansion of periductal space c sclerosis
- storiform fibroblastic prolif [2]
- > 10 IgG4-plasma cells / HPF
Lab: Inc serum IgG4 (>135 mg/dL)
Autoimmune pancreatitis




Autoimmune pancreatitis. (A) IgG staining is negative in type II, (B) IgG4 positive in type 1

Type 2 - Not an IgG4-related disease, (IgG4 serum levels are not elevated), and IgG4 plasma cells not seen, although has dense periductal lymphoplasmacytic infiltrate, Intraepithelial neutrophils and occasional eos also seen (Granulocytic Epitheial Lesions)
- younger pts (5th to 6th decades), M=F, rarely in Asians
IHC: PDL1 in Autoimmune Pancreatitis and Mimics
• Specificity for type 2 AIP -> 95%
• Sensitivity for type 2 AIP–>70%
Reactivity less than 5% in:
– Pancreatic ductal adenocarcinoma
– Type 1 autoimmune pancreatitis
– Other forms of chronic pancreatitis
Type 3 - Mixed???

AIP2 - PDL1 (right) [2]



Chronic pancreatitis
Irreversible destruction of exocrine pancreas c accompanying fibrosis
MCC: EtOH
Micro: loss of acinar cells is a defining feature --> exocrine sx's (diarrhea, malabsorption)
Ductal flow may be obstructed 2/2 fibrosis (caused by repeated bouts of inflam [repeat acute pancreatitis]) and pancreatic concretions (commonly seen in alcoholic pancreatitis)
- pancreatic concretions 2/2 inc [protein] in pancreatic fluid --> dilation c plugging of ducts
Labs: dec fecal elastase (most sensitive and specific)
CXR: calcified parenchyma
Groove Pancreatitis (paraduodenal pancreatitis)
Middle aged men, EtOH abuse
- macroscopic findings are critical
Similar with those of pancreatic carcinoma, may present with Pancreatic head mass, Pancreatic ductal stricture, Duodenal strictures [2]


Nesidioblastosis
Assoc c Beckwith-Wiedmann syndrome
Congenital hyperinsulinemic hypoglycemia 2/2 hyperfunctioning pancreatic beta cells
Cysts
Congenital cysts
Derived from aberrant development of pancreatic ducts
- assoc c ADPKD and vHL
Neoplastic pancreatic cysts
Represent on 1/20 pancreatic neoplasms and <15% of all pancreatic cysts
- can be serous cystadenoma, mucinous custic neoplasms (assoc c invasive adenoca or intraductal papillary mucinous neoplasms)
- MC in men (vs other kinds of cysts)
Follicular pancreatitis
• Mass forming pancreatic lesion
– Rarely mimics an IPMN
Micro: Characterized by reactive lymphoid follicles
– Pancreatic parenchyma
– Main pancreatic duct
Tx: Steroids
– Induction
• Some require steroid sparing agent
– Maintenance
• Steroid sparing agents
– Rituximab
Follicular pancreatitis [2]

Lymphoepithelial cyst
No assoc c HIV or autoimmune conditions (unlike lymphoepithelial cysts of the salivary glands)
Micro: stratified keratinized epithelium surrounded by lymphoid tissue with follicle
- lumen can have keratinous debris and cholesterol crystals
- mucinous cells can be present and sebaceous differentiation can be seen
Labs: 1/2 have inc CA19-9
Tx: conservative, with limited or extended resection
Px: b9, no risk of malig transformation
Lymphoepithelial cyst

Pseudocyst
MCC (~3/4) pancreatic cysts, usually tail of pancreas
- seen c alcoholic pancreatitis
- form due to an accumulation of blood, pancreatic enzymes, and necrotic material usually from some type of pancreatitis
Labs: Inc amylase and lipase
Micro: Contain granular necrotic debris (not mucin), blood, and lots of pancreatic enzymatic juices without a cystic epithelial wall (which is why they are "pseudo"-cysts)
- peripancreatic (just outside the pancreas) and unilocular
- usually resolves spontaneously, though some can be formed 2/2 bacterial infx
Dx: Endoscopic Ultrasound (EUS) - needle guided bx for lesions too small to be id'd by CT/<RI or lesions encased by a vascular structure (making a percutaneous bx difficult)
Cyst fluid analysis [2]:
CEA >800ng/ml (>200ng/ml) --> Neoplastic mucinous cysts
CEA <5ng/ml --> Serous cystadenoma or a Pseudocyst
Amylase <250 U/L --> Not a pseudocyst
Molecular (NGS):
• The distinction of IPMN/MCN from non mucinous cysts of the pancreas
-- KRAS and/or GNAS (IPMN) [Sensitivity > 90%, Specificity > 95%]
• The identification of advanced pancreatic cysts
– TP53 PTEN CDKN2A , SMAD4
• Diagnosis of serous cystadenoma
-- VHL mutations
Tx: drain if lasts > 6wks, painful, or rapidly growing
- debride necrotic tissue

Pseudocyst

Pancreatitis with pseudocyst formation. The pseudocyst is walled off by fibrotic tissue with hemorrhage
Retention cyst
adf


Megacyst
Big, multiloculated cyst (lots of spaces)
DDx: Pseudocyst, MCN


PanIN 3
Pancreatic Intraepithelial Neoplasia (PanIN)
Grossly undetectable (usually <0.5 cm) and often found next to infiltrating neoplasms, thus most likely precedes invasive carcinoma
Broken into 3(.5) stages based on cytogenetic abnormalities:
1A: Columnar cells c telomere shortening and KRAS mutations
1B: same genetics as 1A, but start to form papillary projections
Micro: (1A) flat lesions c tall columnar cells c basal nuclei and lots of supranuclear mucin, c small round oval nuclei
1B: epithelial lesion c papillary, micropapillary or basally pseudostratified architecture; very similar to 1A
- commonly found in resections; do not require tx
2: p16 / CDKN2A inactivation
Histo: mild disorganization, nuclear enlargement and hyperchromasia, pleomorphism, mild dyspolarization of nuclei towards lumen (apically) and rare mits above BM
3: TP53 / SMAD4 / BRCA2 inactivation
Histo: terrible polarity loss, very atypical cells c inc N:C, tufting c detached cell clusters, necrosis and mits
- 3 should be treated as neoplastic
IHC: (+) MUC1, MUC4, DPC4
- neg MUC2, CDX2

Pancreatic Ductal Adenocarcinoma (DA)
MCC (85%) of pancreatic neoplasms
- 4th MCC death from neoplasm in USA
- assoc c BRCA2 mutations, familial P16 multiple mole / melanoma syndrome, Peutz-Jeghers, HNPCC, and hereditary pancreatitis
Presents c PAINLESS JAUNDICE (2/3 in head of pancreas), pain radiating to back, weight loss (from anorexia and malabsorption), palpable gallbladder (Courvoisier's sign) and migratory thrombophlebitis (redness and tenderness on peripheral palpation [Trousseau's syndrome])
- avg age at dx: 63 years
- assoc c cigarrette, but not EtOH use
- inc risk in Jewish and black males
- has usually already met'd at time of presentation
- well-diff tumors can be very difficult to dx on frozen section
Gross: entirely submit tumors <2 cm; else 2 samples per cm
Micro: loss of polarity, nuclear stratification, nuclear hyperchromasia, and prominent nucleoli
- desmoplastic stroma around gland
IHC: (+) CK7, CA19-9, CEA, B72.3, MUC1, MUC5AC, DUPAN2, focal CK20
- neg vimentin, MUC2
- loss of SMAD4/DPC4 is characteristic (though also seen in 1/5 gallbladder ca, 1/10 colon ca)
Labs: CEA and CA19-9
Genes: KRAS mutation (in >9/10), TP53 mutation, SMAD4 inactivation involved in pathogenesis
- may be familial in 1/10 cases
- pts c Peutz-Jeghers syndrome c germline mutation in STK11/LKB1 gene have 132-time increase risk of developing pancreatic cancer
- BRCA2 mutations also put at inc risk
- atypical multiple mole melanoma syndrome assoc c inc risk
Tx: neoadjuvant therapy improves resectability, recurrence-free survival, disease-free survival, and helps deliver chemotherapy pre-surgery
Px: < 6 mo survival (very aggressive)

Mod-diff ductal DA made of larger glands

Mod-diff invasive adenocarcinoma
PDAC: b9 vs malignant

Pancreatic Endocrine Neoplasms (PEN)
- aka Pancreatic Neuroendocrine Tumors (PanNET)
- sometimes called pancreatic islet cell tumors
- 1-2% of pancreatic tumors [1]
Most occur with MEN, tuberous sclerosis, vHL or NF1
- usually are in the tail (where most of the islets are), looking pink and maybe like a big lymph node
- 1/2 are secretory
Insulinoma: 3/4 of PanNET, B-cells, MEN1, clinical triad (?), benign and solitary
Gastrinoma: ~1/4 of PanNETs, MEN1, ZE syndrome, up to 90% are malignant
Glucagonoma: perimenopausal women, MEN1, inc plasma glucagon levels
*** 4 D's: DM, Dermatitis (necrolytic migratory erythema), DVT, Depression ***
- > 50% liver mets at presentation
VIPoma: solitary, large, tail of pancreas, severe diarrhea, hypokalemia, achlorhydria
Somatostatinoma: inc plasma somatostatin, DM, cholelithiasis, diarrhea / steatorrhea
*** Sugar, Stone, Steatorrhea = Somatostatin! ***
Malignant, assoc c MEN1
Micro: small nests or trabeculae of cuboidal cells c central nuclei, stippled chromatin, and granular cytoplasm, growing as trabecular, solid, glandular, gyriform (ribbons and festoons) or nondescript forms (and are histologically classified as such)
- highly vascular stroma
- salt n peppa chromatin
Can secrete multiple types of hormone
IHC: (+) CEA / CEACAM1, individual islet markers (glucagon, insulin...), NSE, chromogranin A / B, synaptophysin, opioid peptides, PR, PAX-8, CD56
- neg: vimentin, acinar markers (trypsin, chymotrypsin, PAS/D), CD10 (1/10+), nuclear B-catenin, ER
Px: dependent on Size and Mitotic / Ki67 levels
- most are low grade (well-differentiated and solitary)
Pancreatic endocrine neoplasms (PEN) - tumor on the right pushes the non-neoplastic pancreatic parenchyma on the left of the arrowheads

PanNET

Acinar Cell Carcinoma
MC in older adults (60 yo), 1-2% of pancreatic neoplasms in adults, up to 15% of pancreatic neoplasms in children, 2M>1F, assoc c skin rash
Gross: can occur anywhere in pancreas, but MC In head; large (10 cm) well-circumscribed, fleshy c areas of necrosis
- may have large areas of necrosis 2/2 lipase secretion (causing skin rash, subcutaneous fat necrosis, and polyarthralgia when metastatic)
Micro: Uniform large cells c prominent nucleolus and bluish cytoplasm w/o surrounding desmoplastic rxn
- can grow in acinar, solid, trabecular, glandular, or papillary patterns
- have PAS(+) / diastase resistant cytoplasmic zymogen granules
IHC: (+) BCL10, trypsin, lipase, chymotrypsin, cytokeratins (Cam5.2), may stain for neuroendocrine markers
- negative CHR/SYN (var), CD10, CEA, nuclear B-catenin
BCL10 sensitive and specific (recognized COOH-terminal of carboxyl ester lipase, an enzyme produced by pancreatic acinar cells)
Genes: APC/B-catenin mutation and -11p (similar to pancreatoblastoma); no hallmark genetic alteration
DDx: pancreatic neuroendocrine tumor, pancreatoblastoma, solid pseudopapillary neoplasm
Px: highly aggressive, 25% 5-year survival
- mets present in 1/2 of cases at diagnosis, usually to liver and regional lymph nodes
Acinar cell carcinoma


Mixed acinar carcinoma
Rare, defined as a neoplasm with more than 30% of each line of differentiation in addition to a major acinar cell carcinoma component
MC is the Mixed Acinar-Neuroendocrine Carcinoma (MANEC)
- diagnosed on basis of coexpession of acinar and neuroendocrine markers
- the neuroendocrine features may not be evident morphologically and therefore the use of IHC is mandatory
- best regarded as a subtype of acinar cell carcinoma because of the shared clinical behavior and genomic features
Colloid carcinoma
>80% of tumor is mucinous with scant floating tumor cells
- assoc c intraductal papillary mucinous neoplasm (virtually always arises in an intestinal type IPMN), mucinous cystic neoplasm (MCN) and ampullary / duodenal tubulovillous adenoma
- usually head of pancreas
- may be complicated by pseudomyxoma peritonei
Gross: large, well-demarcated
Micro: >80% shows large extracellular stromal mucin pools with scant carcinoma cells floating in mucin pools
- carcinoma cells usually cuboidal / columnar with cribriforming, strips of cells or signet ring cells
Extravasated mucin does NOT equal invasive carcinoma
- find IPMN
IHC: (+) CDX2, MUC2, CEA in basal aspect of cells, focal SYN or CHR ok
- neg MUC1
DDx: cPDAC (MUC2-)
Px: probably better than conventional pancreatic ductal adenocarcinoma (cPDAC); 5-yr survival up to 72%
- expression of MUC2 (gel forming mucin, rare in cPDAC) and absence of external lamina or basement membrane may lead to accumulation of extracellular mucin, which limits tumor spread and apears to have tumor suppressor activity


Pancreatoblastoma
MCC pancreatic cancer in Asian kids (~4 yo), but overall is rare
- may be assoc c FAP and Beckwith-Wiedmann syndromes
- can come from acini, ducts, or endocrine cells
-- basically is the kid version of acinar cell ca
Labs: inc serum AFP (b/c is a primitive-type of tumor)
Gross: Large (10 cm), well-demarcated, solid, multilobulated
Micro: Cellular sheets of round cells c nuclear inclusions and squamoid corpuscles
- corpuscles have clear nuclei due to biotin accumulation
- epithelial parts can have acinar, solid or squamoid nests
IHC: (+) CK AE1/3, trypsin, lipase, CEA, synaptophysin, chromogranin, NSE, B-catenin, chromogranin,
- squamoid corpuscles: (+) CK8/18/19, cyclin D1, EMA and are CK7 negative
- may show some positivity with BCL10 in the acinar component (do not confuse with acinar cell tumor)
Genes: most common genetic alteration is loss of heterozygosity of chromosome 11p
- like acinar cell ca, can have mutated B-catenin (CTNNB1) or APC gene
- may have alterations in the Wnt pathway and allelic loss on 11p
- also has loss of heterozygosity of 11p (as in Wilms tumor and hepatoblastoma; both of which can be part of Beckwith-Weidmann syndrome)
Px: Poor (25% 5-year survival) [?], sometimes favorable
Pancreatoblastoma c squamoid corpuscle

Pacnreatoblastoma with squamous nests

Serous (microcystic) cystadenoma
MC in women; also assoc c vHL, head of pancreas
Gross: so many little cysts looks like a well-circumscribed sponge
- MC in body / tail; often has a central stellate scar
- large size and location in the head predict aggressive behavior
Imaging: pancreatic head, has typical "honey-comb" appearance 2/2 large numbers of cystic spaces
Cyst fluid analysis [2]:
CEA >800ng/ml (>200ng/ml) --> Neoplastic mucinous cysts
CEA <5ng/ml --> Serous cystadenoma or a Pseudocyst
Amylase <250 U/L --> Not a pseudocyst
Micro: Simple cuboidal epithelial layer filled c glycogen (clear-cells)
IHC: (+) alpha-inhibin, CAM5.2, CK7/8/18/19, MUC6, EMA (1/3), calponin
- negative serum CEA, CA19-9, CA125, CD31, Factor VIII
Genes: vHL and cr 10q translocations
Molecular (NGS):
• The distinction of IPMN/MCN from non mucinous cysts of the pancreas
-- KRAS and/or GNAS (IPMN) [Sensitivity > 90%, Specificity > 95%]
• The identification of advanced pancreatic cysts
– TP53 PTEN CDKN2A , SMAD4
• Diagnosis of serous cystadenoma
-- VHL mutations
Px: Benign, does not recur


Serous (microcystic) cystadenoma

Mucinous cystic neoplasms (MCN)
Almost always in perimenopausal women
- tumor does not communicate with pancreatic ductal system (vs IPMN)
Gross: MC in pancreatic tail c multiloculated cysts filled c mucin
Micro: lined by tall, simple cuboidal epithelium on top of a stroma so dense it looks like ovary
- smear is hypocellular, has thick mucous and columnar cells and is CEA (+)
- if cell lining is very atypical or glands are invading into capsule or beyond, dx is mucinous cystadenocarcinoma
- can see gastric foveolar, pseudopyloric, small and large intestine-type epithelium
- can grade dysplasia as low, medium, or high
IHC: (+) SMA/inhibin /ER/PR in ovarian stroma, cytoplasmic PAS, CEA/EMA and CK 19/7/8/18 in epithelial cells
Genes: mutated p53 and RNF43 tumor suppressor genes and KRAS oncogene, also SMAD4/DPC4
- however these tumors rarely show (+) nuclear P53 on IHC, though can be positive in malignant variants (?)
Molecular (NGS):
• The distinction of IPMN/MCN from non mucinous cysts of the pancreas
-- KRAS and/or GNAS (IPMN) [Sensitivity > 90%, Specificity > 95%]
• The identification of advanced pancreatic cysts
– TP53 PTEN CDKN2A , SMAD4
• Diagnosis of serous cystadenoma
-- VHL mutations
Tx: Excision is sufficient, except for those found to have carcinoma
Px: ~1/3 have invasive carcinoma (mucinous cystadenocarcinoma), thus it is of utmost importance to remove ASAP
- 1/2 of pts c carcinoma die from the tumor; usually mets are local to peritoneum or ovary

Benign MCN

MCN
Large Duct Type Invasive Ductal Pancreatic Adenocarcinoma
Can look a lot like IPMN [2]

IPMN vs Large Duct Type PDAC [2]

Intraductal Papillary Mucinous Neoplasm (IPMN)
MC in elderly pts, esp male smokers
- spectrum of behavior from benign, to borderline to malignant
IPMN issues to address:
• Invasion Yes/No
• Grade Low/High
• Type Gastric, intestinal, pancreatobilliary
• Main duct versus branch duct
Gross: mucous-producing tumors found in the larger ducts in the head of the pancreas and can be multifocal
- intraductal cystic dilatation c mucinous lining
Micro: distinguished from mucinous cystic neoplasm by lack of dense "ovarian"-type stroma and involvement of the ducts
IHC: (+) MUC2, CDX2, S100p
- MUC1
- has intestinal phenotype
Genes: mutated KRAS / GNAS oncogenes and TP53,p16, SMAD4, and RNF43 tumor suppressor genes
Tx: IPMN is generally not an indication for neoadjuvant therapy
• Remind your clinicians: Adenocarcinoma ≠ Invasion
Px: spread slowly throughout the ductal system and finally lead to invasive carcinoma (in ~1/3 of resections)

IPMN
IPMN resection criteria [2]


Oncocytic-type Intraductal Papillary Mucinous Neoplasm
- previously Intraductal Oncocytic Papillary Neoplasm
Rare subtype of IPMN first seen in case series in 1996
- most have enough cytoarchitectural atypia to be called HG-dysplasia or carcinoma in situ, and invasive ca can arise also
Micro: eosinophilic neoplasm c complex arborizing papillae, cribriform or solid foci
- papillae lined by several layers of cuboidal or columnae cells
- consistently has abundant granular, eosinophilic cytoplasm from accumulation of mitochondria
IHC: (+) MUC6, CK7, HepPar1, anti-mitochondrial stains
- neg CK20 and CDX2`
Intraductal oncocytic papillary neoplasm

Medullary carcinoma
Very rare tumor; assoc c microsatellite instability (1/2), colonic aca, and family history of cancer
Micro: sheets of carcinoma cells c abundant cytoplasm, large vesicular nuclei with prominent nucleoli, intraepithelial lymphocyte infiltration
Genes: usually no KRAS mutations but 1/5 have inactivation of DNA mismatch repair system
Px: Good

Osteoclast-like Giant Cell Carcinoma (OGCC)
- undifferentiated carcinoma c osteoclast-like GCs; is a subtype of ductal adenocarcinoma with prominent osteoclast-like giant cells
Gross: well-circumscribed
Micro: large pleomorphic spindle cells and giant cells in a background of scant fibrous stroma and hemorrhage
- giant cells vary in size and osteoclast-like giant cells are present
IHC: (+) CD45/68 in giant cells
- neg keratin in giant cells
- undifferentiated carcinoma is claudin 4 positive, whereas undifferentiated sarcoma is clauding 4 negative [2]
Genes: KRAS mutation in 90%
- TP53 and HER-2/NEU also seen
DDx: mets
Tx: Treatment is similar to pancreatic ductal adenocarcinoma
Px: clinical behavior is unpredictable
– Some patients behave similar to pancreatic ductal
adenocarcinoma
– Other patients behave unexpectedly well
- Histopathological features such as tumor grade and level of cellular atypia do not adequately predict outcome

Undifferentiated carcinoma, osteoclast-like giant cell type
Undifferentiated carcinoma with osteoclast-type giant cells [2]
Solid PseudoPapillary Neoplasm (SPPN)
MC in young (30 yo) women (9:1 F:M), usually tail of pancreas
Gross: Usually has a good capsule, but can have micro-infiltration
Micro: Pseudopapillae covered in several layer of endothelial cells
- nuclei are oval and folded up with grooves
- cells farthest away from vasculature are dyscohesive and necrotic
- also can see Hyaline globules and some (foamy) macrophages
IHC: (+) nuclear B-catenin, CD10 / 56, vimentin (10/10), claudin, progesterone receptor (PR)
- neg: CK (var) [1], CHR, ER, trypsin
- cystic fluid will be CEA negative
Genes: Uniformly have B-catenin (CTNNB1) mutation and cyclin D1 overexpression
Tx: 9/10 pts are cured c excision; the rest may have mets to liver or peritoneum
Px: excellent
SPPN


References
1. SPN Collides with a Well-Differentiated Pancreatic Endocrine Neoplasm in an Adult Man. AJCP Feb 2015; p283-287
2. LASOP meeting 1-2022
